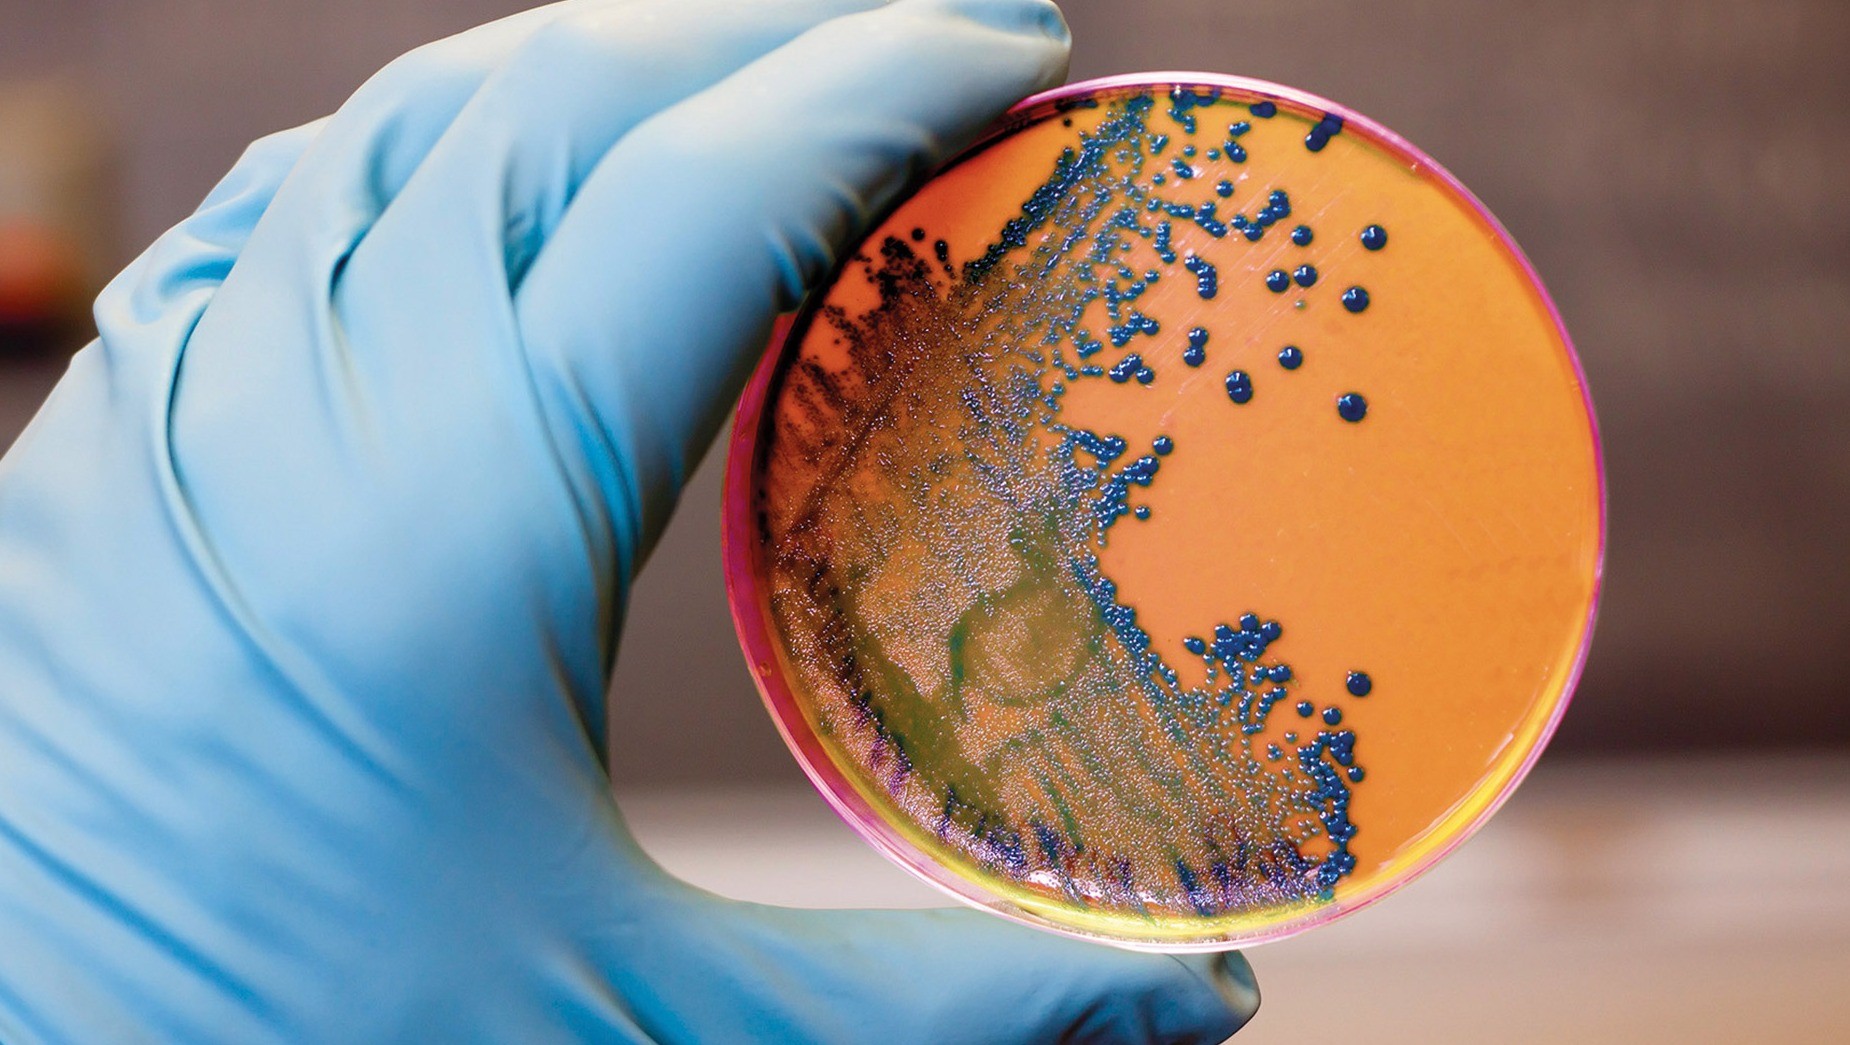

Чем опасна листерия
Прогноз от фобос великий новгород
Детка вытри
Социал демократическая партия 19 век
17 21x 9 14 5 21
Ржаница бежица
Ангел тату на плече эскиз
У тебя в глазах лето отражается
У меня который год кашалот живой
Я парировал все время манга читать
Zombie сайт кресла
Бортовой компьютер планшет
Concept fresh up color
Все версии санса
Чем опасна листерия 117 фото